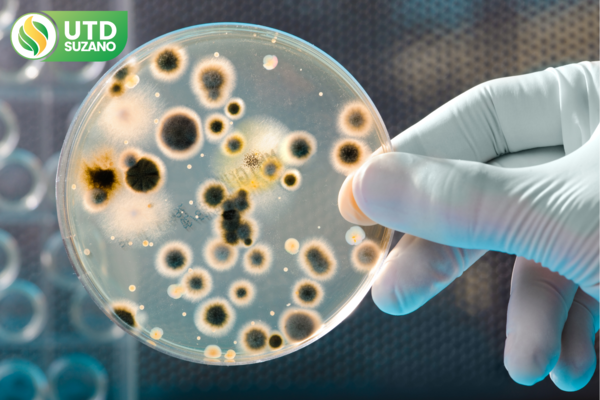

Waste Categories

Hospital
Hospital waste, such as sharps and chemical products, must be separated and collected in accordance with selective collection standards to ensure safe and environmentally responsible management.

PPE
PPE waste, such as gloves and masks, must be segregated and collected according to selective collection guidelines, ensuring adequate and sustainable disposal.

Expired Medications
Waste from expired medicines must be separated and sent through specialized selective collection, ensuring safe disposal and in compliance with environmental regulations.

Dental Waste
Dental waste, such as amalgams and needles, must be collected following specialized selective collection procedures, contributing to correct and environmentally responsible disposal.
Bacteriological
Bacteriological residues must be collected through specific selective collection processes, ensuring safe and sanitary handling. See examples on our website for more detailed information.

PET
The collection of animal carcass waste is carried out with extreme attention to hygiene and in compliance with specific regulations. Our approach ensures that this waste is properly collected and disposed of, minimizing environmental impacts and health risks

Tattoo Studio
Tattoo studio waste is generally waste from Group A (potentially infectious, with the presence of biological agents), Group B (paints) and Group E (sharps, such as needles and syringes) must be collected according to specific disposal guidelines, aiming at safety and health.

Industrial
Industrial waste such as metals, rubber, fabrics and gases must be collected following specialized protocols to ensure compliance and sustainability.



